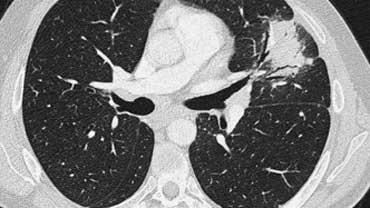
Slider image 1
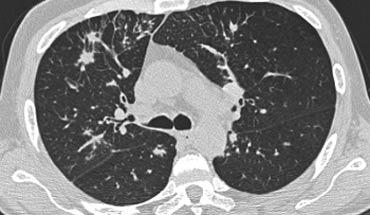
Slider image 1

HRCT – Chẩn đoán thường gặp
Trong bài ‘HRCT – Đọc phim cơ bản‘, thuật ngữ chuyên ngành được giới thiệu cùng với hướng dẫn tiếp cận thực hành trong đọc phim HRCT.
Giới thiệu
Có hơn 100 thực thể bệnh lý biểu hiện dưới dạng bệnh phổi lan tỏa.
May mắn thay, chỉ khoảng 10 trong số đó chiếm tới khoảng 90% tổng số các trường hợp bệnh phổi lan tỏa được đánh giá qua sinh thiết phổi mở.
Việc nắm vững các hình ảnh HRCT điển hình cũng như không điển hình của những bệnh phổi lan tỏa thường gặp này là cực kỳ quan trọng.
Ở bên trái là ba danh sách chẩn đoán khác nhau.
Các danh sách này chiếm từ 80 đến 90% tổng số chẩn đoán theo nhiều tài liệu tham khảo y văn.
Trong một số danh sách, tên cũ được sử dụng, trong khi một số khác dùng tên mới hơn.
Từ gợi nhớ (mnemonic) cho danh sách đầu tiên là ‘SHIT FACED’ (hoặc thay thế bằng ‘shaded fit’).
Sarcoidosis
Hai phần ba bệnh nhân có thể lui bệnh trong vòng mười năm.
Một phần ba có bệnh tiến triển liên tục dẫn đến suy giảm chức năng cơ quan có ý nghĩa lâm sàng.
Ít hơn 5% bệnh nhân tử vong do sarcoidosis, thường là hậu quả của xơ phổi.
Phân giai đoạn
Hình ảnh X-quang ngực trong sarcoidosis được phân thành bốn giai đoạn:
- Hạch to rốn phổi hai bên
- Hạch to rốn phổi hai bên + tổn thương nhu mô phổi
- Chỉ có tổn thương nhu mô phổi
- Xơ hóa không hồi phục
Các giai đoạn này không phản ánh mức độ mạn tính của bệnh cũng như không tương quan với sự thay đổi chức năng hô hấp.
Hình ảnh
Bệnh nhân ở giai đoạn I.
Có hạch to rốn phổi và cạnh khí quản, không có dấu hiệu tổn thương nhu mô phổi.

Sarcoidosis: hình ảnh điển hình với các nốt dọc theo bó mạch phế quản và các khe liên thùy. Lưu ý hạch vôi hóa một phần ở rốn phổi trái.
Dấu hiệu HRCT trong Sarcoidosis
- Dấu hiệu thường gặp:
- Các nốt nhỏ phân bố theo đường bạch huyết (dọc theo bề mặt dưới màng phổi và các khe liên thùy, dọc theo vách liên tiểu thùy và bó mạch phế quản).
- Ưu thế ở vùng trên và giữa phổi.
- Hạch to ở rốn phổi trái, rốn phổi phải và cạnh khí quản (dấu hiệu 1-2-3). Thường kèm vôi hóa.
- Dấu hiệu ít gặp:
- Các khối hợp lưu ở vị trí quanh rốn phổi.
- Các nốt lớn hơn (> 1cm đường kính), dạng nốt tập hợp hoặc nốt hợp lưu được bao quanh bởi nhiều nốt vệ tinh (dấu hiệu Galaxy)
- Các nốt quá nhỏ và dày đặc đến mức có hình ảnh kính mờ hoặc thậm chí đông đặc (sarcoidosis phế nang)
Hình ảnh
Hình ảnh điển hình của sarcoidosis với hạch to rốn phổi và các nốt nhỏ dọc theo bó mạch phế quản (mũi tên vàng) và dọc theo các khe liên thùy (mũi tên đỏ).
Hình ảnh
Hình ảnh chi tiết với biểu hiện HRCT điển hình gồm các nốt dọc theo bó mạch phế quản (mũi tên đỏ) và các khe liên thùy (mũi tên vàng).
Đây là phân bố theo đường bạch huyết điển hình của các nốt.
Hình ảnh HRCT của sarcoidosis phổi rất đa dạng và được biết đến là có thể bắt chước nhiều bệnh phổi thâm nhiễm lan tỏa khác.
Khoảng 60 đến 70% bệnh nhân sarcoidosis có hình ảnh X-quang đặc trưng.
Trong 25 đến 30% trường hợp, hình ảnh X-quang không điển hình.
Ở 5 đến 10% bệnh nhân, X-quang ngực bình thường.
Bên trái là một hình ảnh điển hình khác của sarcoidosis với hạch to trung thất và các nốt nhỏ phân bố theo đường bạch huyết dọc theo bó mạch phế quản và dọc theo các khe liên thùy (mũi tên vàng).
Luôn tìm kiếm các nốt nhỏ dọc theo các khe liên thùy, vì đây là dấu hiệu rất đặc hiệu và điển hình của sarcoidosis.
Xơ hóa trong Sarcoidosis.
Xơ hóa tiến triển trong sarcoidosis có thể dẫn đến các khối hợp lưu mô xơ quanh phế quản mạch máu (quanh rốn phổi).
Vị trí điển hình là ở phần sau của thùy trên, gây mất thể tích thùy trên kèm di lệch khe liên thùy.
Các bệnh khác thường có hình ảnh tương tự bao gồm:
- Bệnh bụi phổi silic
- Lao phổi
- Bệnh bụi phổi talc
Đây là hình ảnh X-quang ngực điển hình của sarcoidosis giai đoạn muộn (giai đoạn IV) với xơ hóa ở vùng trên phổi và mất thể tích thùy trên dẫn đến nâng cao rốn phổi.
Xơ hóa gây tắc nghẽn các mạch máu phổi, có thể dẫn đến tăng áp động mạch phổi.
Đây là một trường hợp khác của sarcoidosis giai đoạn IV.
Lưu ý sự phân bố của các khối hợp lưu xơ hóa ở phần sau của phổi.
Ngoài ra còn có nhiều nốt nhỏ bờ rõ.
Một số nốt trong số này có phân bố dưới màng phổi điển hình.
Sarcoidosis phế nang.
Đây là một trường hợp sarcoidosis phế nang.
Hãy cuộn qua các hình ảnh.
Hình ảnh trông giống như tăng tỷ trọng dạng kính mờ, nhưng khi quan sát kỹ hơn có thể nhận thấy rằng sự tăng tỷ trọng này là kết quả của nhiều nốt nhỏ tập hợp lại.
Cũng lưu ý hạch to rốn phổi.
Sarcoidosis phế nang (2)
Bên trái là bệnh nhân nữ 47 tuổi với triệu chứng ho khan, khó thở nhẹ và xét nghiệm máu bình thường.
Bệnh nhân được chụp X-quang ngực và điều trị kháng sinh.
Phim kiểm tra được chụp lại do bệnh nhân không cải thiện.
Phim X-quang ngực đầu tiên cho thấy đông đặc hai bên ở thùy dưới (mũi tên), ban đầu được diễn giải là nhiễm trùng.
Sau hai tuần điều trị kháng sinh, không có cải thiện.
Chẩn đoán phân biệt lúc này bao gồm u ác tính (ung thư phế quản phế nang hoặc u lympho), viêm phổi tăng bạch cầu ái toan, viêm phổi tổ chức hóa, bệnh Wegener hoặc một thể không điển hình của sarcoidosis.
Tiếp tục với hình ảnh HRCT.
Hãy cuộn qua các hình ảnh bên trái.
Có nhiều vùng đông đặc.
Các dấu hiệu kèm theo bao gồm hạch to rốn phổi và trung thất.
Chẩn đoán phân biệt trên hình ảnh CT về cơ bản giống như trên X-quang ngực.
Kết quả mô bệnh học xác nhận sarcoidosis phế nang.
Chỉ có một gợi ý duy nhất cho chẩn đoán, đó là sự hiện diện của các nốt nhỏ có thể nhận thấy ở hình 3, nhưng rất khó quan sát.
Trường hợp này minh họa rõ ràng rằng sarcoidosis thực sự là “kẻ bắt chước vĩ đại”.
Do đó, sarcoidosis cần được đưa vào danh sách chẩn đoán phân biệt của chúng ta!
Bên trái là một trường hợp sarcoidosis xơ hóa, cho thấy hình ảnh xơ hóa, giãn phế quản do co kéo và sự tập trung các phế quản bị tổn thương, chủ yếu ở vùng quanh rốn phổi và thùy trên.
Không có bất thường dạng nốt, nhưng hình ảnh và vị trí của xơ hóa rất gợi ý chẩn đoán sarcoidosis.

Bệnh bụi phổi silic / Bệnh bụi phổi than ở thợ mỏ
Bệnh bụi phổi silic và bệnh bụi phổi than ở thợ mỏ (CWP) là hai thực thể bệnh lý riêng biệt với mô học khác nhau, phát sinh do hít phải các loại bụi vô cơ khác nhau.
Tuy nhiên, hình ảnh X-quang và HRCT của hai bệnh này có thể không phân biệt được với nhau và có thể tương tự như bệnh sarcoidosis.
Điều quan trọng cần nhận thức là các bệnh này hiếm gặp hơn so với sarcoidosis.
Bệnh bụi phổi silic và CWP xảy ra ở một nhóm bệnh nhân đặc thù (công nhân xây dựng, công nhân khai thác mỏ, công nhân tiếp xúc với phun cát, thổi thủy tinh và làm gốm sứ).
Dấu hiệu HRCT trong bệnh bụi phổi silic/CWP
- Các nốt nhỏ bờ rõ, đường kính từ 2 đến 5mm, xuất hiện ở cả hai phổi.
- Ưu thế ở thùy trên
- Các nốt có thể bị vôi hóa
- Phân bố trung tiểu thùy và dưới màng phổi
- Đôi khi có phân bố ngẫu nhiên
- Các khối tập hợp không đều, được gọi là xơ hóa khối tiến triển (progressive massive fibrosis)
- Các khối có thể tạo hang do hoại tử thiếu máu cục bộ.
- Thường có hạch bạch huyết rốn phổi và trung thất.
Hình bên trái là một trường hợp bệnh bụi phổi silic cho thấy các nốt có kích thước khác nhau với phân bố ngẫu nhiên và dưới màng phổi.
Một nốt có chứa vôi hóa (mũi tên).
Lưu ý sự vắng mặt của kiểu phân bố theo đường bạch huyết (quanh phế quản-mạch máu và dọc theo các khe liên thùy), vốn là gợi ý của bệnh sarcoidosis.

Cùng bệnh nhân bụi phổi silic như các hình trước, cho thấy một khối tập hợp ở vị trí cạnh rốn phổi thuộc thùy trên phổi phải. Thùy trái cho thấy nhiều nốt có kích thước khác nhau.
Chẩn đoán phân biệt bệnh bụi phổi silic / Bệnh bụi phổi.
- Sarcoidosis: có thể khó phân biệt (chú ý đến phân bố của các nốt).
- Nhiễm trùng: lao kê, nấm.
- Di căn theo đường máu: các nốt bụi phổi silic ở vị trí dưới màng phổi và quanh tiểu phế quản đến mức tiểu thùy phổi thứ cấp, có thể có phân bố có vẻ ngẫu nhiên và mô phỏng di căn cũng như nhiễm trùng dạng kê.
- Bệnh mô bào Langerhans: có thể khó phân biệt với bệnh bụi phổi silic ở giai đoạn sớm, khi LCH chỉ đặc trưng bởi sự hiện diện của các nốt nhỏ. Chú ý tìm các nốt có tạo hang.
Ung thư hạch bạch huyết lan tỏa (Lymphangitic Carcinomatosis)
Ung thư hạch bạch huyết lan tỏa (Lymphangitic Carcinomatosis) là hậu quả của sự lan rộng theo đường máu đến phổi, tiếp theo là xâm lấn vào mô kẽ và hệ bạch huyết.
Các triệu chứng khởi phát bao gồm khó thở và ho, có thể xuất hiện trước khi có bất thường trên hình ảnh X-quang.
Tuy nhiên, trong nhiều trường hợp, bệnh nhân hoàn toàn không có triệu chứng.
Ung thư hạch bạch huyết lan tỏa thường gặp trong ung thư phổi, vú, dạ dày, tụy, tuyến tiền liệt, cổ tử cung, tuyến giáp và ung thư biểu mô tuyến di căn từ nguyên phát không rõ nguồn gốc.
Dấu hiệu HRCT trong Ung thư hạch bạch huyết lan tỏa
- Dày vách liên tiểu thùy, dày các khe liên thùy và dày mô kẽ quanh phế quản-mạch máu (dấu hiệu “bronchial cuffing”).
- Tùy thuộc vào việc lấp đầy bởi dịch hay tế bào khối u, dày vách có thể không đều hoặc nhẵn.
- Bất thường khu trú hoặc một bên trong 50% bệnh nhân.
- Hạch bạch huyết rốn phổi to trong 50% bệnh nhân.
- Tràn dịch màng phổi do ung thư màng phổi lan tỏa ( > 50% bệnh nhân).
Hình ảnh
Bệnh nhân với Ung thư hạch bạch huyết lan tỏa.
Lưu ý phân bố khu trú của tổn thương.
Đặc điểm này có giá trị trong việc phân biệt Ung thư hạch bạch huyết lan tỏa với các nguyên nhân khác gây dày vách liên tiểu thùy như phù phổi hoặc sarcoidosis.
Ngoài ra còn có hình ảnh hạch to.
Hình ảnh
Bệnh nhân khác với Ung thư hạch bạch huyết lan tỏa có dày vách liên tiểu thùy (mũi tên vàng).
Kèm theo tràn dịch màng phổi (mũi tên xanh) và tổn thương di căn phổi (vòng tròn).
Ví dụ về Ung thư hạch bạch huyết lan tỏa và chẩn đoán phân biệt
- Ung thư hạch bạch huyết lan tỏa: dày vách không đều, thường khu trú hoặc một bên, hạch to trong 50% trường hợp, có tiền sử ung thư đã biết.
- Phù phổi do tim: bất thường hai bên, lấp đầy phế nang, tim to, đáp ứng nhanh với thuốc lợi tiểu, kính mờ (ground-glass opacity) do phế nang lấp đầy dịch, phân bố dịch phế nang theo trọng lực.
- Ung thư hạch bạch huyết lan tỏa.
- Ung thư hạch bạch huyết lan tỏa kèm hạch rốn phổi to và dày mô kẽ quanh phế quản-mạch máu trung tâm.
- Protein phế nang (Alveolar proteinosis): các tiểu thùy thứ cấp giới hạn rõ với đậm độ kính mờ tương phản với các tiểu thùy thứ cấp thông khí bình thường, dày vách liên tiểu thùy và nội tiểu thùy chồng lên nhau (hình ảnh “crazy paving”).
- Phù phổi do tim.
Phù phổi do tim (Cardiogenic pulmonary edema)
Bệnh nhân phù phổi thường không được chụp HRCT vì chẩn đoán thường dựa trên sự kết hợp giữa các dấu hiệu lâm sàng và hình ảnh X-quang ngực thẳng.
Tuy nhiên, đôi khi chẩn đoán không đơn giản như vậy, và việc nắm vững hình ảnh HRCT của phù phổi có thể hữu ích trong việc tránh chẩn đoán nhầm.
Dấu hiệu HRCT trong phù phổi do tim
- Dày vách liên tiểu thùy hai bên và mờ dạng kính mờ (ground-glass opacity).
- Phân bố chủ yếu ở vùng quanh rốn phổi và vùng thấp (phụ thuộc trọng lực) của phổi.
- Tim to và tràn dịch màng phổi.
Hình bên trái minh họa các đặc điểm điển hình của phù phổi do tim.
Có hình ảnh dày vách liên tiểu thùy đều đặn và một số vùng mờ dạng kính mờ ở phần thấp của phổi.
Ngoài ra, có hình ảnh tràn dịch màng phổi hai bên.
Ở bệnh nhân có tiền sử ác tính đã biết, ung thư di căn dạng viêm bạch mạch (lymphangitic carcinomatosis) cần được đặt lên hàng đầu trong chẩn đoán phân biệt.
Chẩn đoán phân biệt phù phổi do tim.
- Ung thư di căn dạng viêm bạch mạch (Lymphangitic carcinomatosis)
- Viêm phổi kẽ (do virus, Mycoplasma)
- Hội chứng suy hô hấp cấp tiến triển (ARDS)
- Xuất huyết phổi
Hình bên trái là một ví dụ khác về phù phổi do tim.
Bệnh nhân này được chụp CT để loại trừ thuyên tắc phổi.
Có hình ảnh dày vách liên tiểu thùy đều đặn và mờ dạng kính mờ với phân bố dạng đốm không đều.
Lưu ý: phù phổi có thể có hình ảnh rất không điển hình và phân bố rất không đồng đều — một số vùng bị lấp đầy dịch trong khi các vùng lân cận ngay bên cạnh lại có hình ảnh hoàn toàn bình thường.
Viêm Phổi Quá Mẫn
Viêm phổi quá mẫn (HP) còn được gọi là viêm phế nang dị ứng ngoại sinh (EAA).
HP là bệnh phổi dị ứng do hít phải nhiều loại kháng nguyên khác nhau (phổi người nông dân, phổi người nuôi chim, phổi do bồn tắm nước nóng, phổi do máy tạo độ ẩm).
Các bất thường trên hình ảnh X-quang và mô bệnh học ở bệnh nhân có thể được phân loại thành giai đoạn cấp tính, bán cấp và mạn tính.
HRCT thường được thực hiện trong giai đoạn bán cấp của HP, từ vài tuần đến vài tháng sau lần tiếp xúc đầu tiên với kháng nguyên, hoặc trong giai đoạn mạn tính.
Viêm phổi quá mẫn bán cấp
Các dấu hiệu chính trong viêm phổi quá mẫn bán cấp bao gồm:
- Các nốt trung tâm tiểu thùy bờ không rõ có dạng kính mờ (80% các trường hợp) hoặc
- Hình ảnh khảm kết hợp giữa vùng kính mờ dạng đốm do thâm nhiễm phổi và vùng sáng dạng đốm do viêm tiểu phế quản với bẫy khí
Dưới đây là hai ví dụ về viêm phổi quá mẫn bán cấp.
Có thể thấy các nốt trung tâm tiểu thùy bờ không rõ dạng kính mờ.
Đây là một trường hợp khác của viêm phổi quá mẫn bán cấp.
Có thể thấy hình mờ mờ nhạt ở trung tâm các tiểu thùy thứ cấp (mũi tên) với vùng dưới màng phổi được bảo tồn.
Hình ảnh HRCT này cũng cho thấy hình mờ trung tâm tiểu thùy mờ nhạt ở bệnh nhân HP bán cấp.
Lưu ý ranh giới không rõ của các nốt trung tâm tiểu thùy này.
Đôi khi các hình mờ trung tâm tiểu thùy có hình thái dạng nốt rõ hơn như trong trường hợp này.
Đây là một trường hợp khác của viêm phổi quá mẫn.
Có hình ảnh khảm.
Một số tiểu thùy thứ cấp biểu hiện kính mờ do thâm nhiễm phổi, trong khi các tiểu thùy khác sáng hơn do viêm tiểu phế quản với bẫy khí.
Bệnh nhân này nhập viện với triệu chứng khó thở cấp tính và phim X-quang ngực bình thường (không trình bày).
HRCT lúc nhập viện (trái) cho thấy các vùng kính mờ theo phân bố tiểu thùy.
HRCT kiểm tra mười ngày sau (phải) cho thấy các tổn thương đã thoái lui hoàn toàn mà không cần điều trị.
Các tổn thương được cho là do viêm phổi quá mẫn.
Viêm phổi quá mẫn mạn tính
Các dấu hiệu chính trong viêm phổi quá mẫn mạn tính bao gồm:
- Hình ảnh khảm với các vùng kính mờ và các vùng giảm tỷ trọng.
- Xơ hóa và biến dạng nhu mô phân bố chủ yếu ở vùng giữa phổi.
Bên trái là hình ảnh của bệnh nhân viêm phổi quá mẫn mạn tính.
HRCT cho thấy hình ảnh khảm với các tiểu thùy thứ cấp ứ khí và các tiểu thùy thứ cấp tăng tỷ trọng.
Ngoài ra còn có dày vách liên tiểu thùy và lưới nội tiểu thùy, gợi ý xơ hóa không hồi phục đã hình thành.
Chẩn đoán phân biệt của Viêm phổi quá mẫn.
-
Giai đoạn bán cấp:
- RB-ILD: gặp ở người hút thuốc, ưu thế ở thùy trên, thường kèm theo khí phế thũng trung tâm tiểu thùy.
- Protein phế nang.
-
Giai đoạn mạn tính:
-
UIP: có thể có hình ảnh HRCT rất tương đồng.
UIP có phân bố ưu thế ở vùng phổi dưới.
Trong HP mạn tính, các thay đổi xơ hóa thường gặp trên toàn bộ nhu mô phổi từ ngoại vi đến trung tâm.
-
UIP: có thể có hình ảnh HRCT rất tương đồng.
Viêm phổi quá mẫn mạn tính (2)
Trường hợp bên trái cho thấy hình ảnh chụp thì hít vào và thở ra: hình ảnh khảm với các vùng kính mờ và các vùng giảm tỷ trọng trở nên rõ ràng hơn trên ảnh thở ra, gợi ý bẫy khí.
Các dấu hiệu xơ hóa như biến dạng mạch máu và phế quản cũng như dày vách liên tiểu thùy rõ hơn ở vùng giữa và dưới phổi, nhưng không giới hạn ở vùng dưới màng phổi.
Các hình ảnh bên trái gợi ý chẩn đoán viêm phổi quá mẫn.
Dựa trên hình ảnh học đơn thuần, protein phế nang và các bệnh lý khác có hình ảnh khảm cần được đưa vào chẩn đoán phân biệt.
Lao phổi (Tuberculosis)
Lao nguyên phát (Primary TB):
Nhiễm trùng lần đầu với biểu hiện đông đặc phổi, hạch to và tràn dịch màng phổi.
Lao thứ phát (Secondary TB):
Lao sau nguyên phát hoặc lao tái hoạt động.
Đây là sự tái hoạt của ổ nhiễm trùng ban đầu.
Thường khu trú tại các phân thùy đỉnh của thùy trên với hình ảnh tạo hang.
Lan tràn qua đường phế quản (Endobronchial spread): Có thể xảy ra trong cả lao nguyên phát và thứ phát, khi nhiễm trùng không được kiểm soát.
Lan tràn theo đường máu (Lao kê – Miliary TB): Có thể xảy ra trong cả lao nguyên phát và thứ phát, khi nhiễm trùng không được kiểm soát.
Hình ảnh HRCT trong lao phổi
-
Lao nguyên phát:
- Đông đặc phổi ở bất kỳ vị trí nào, hạch bạch huyết to và tràn dịch màng phổi. Thường thoái triển thành nốt phổi vôi hóa và hạch bạch huyết cùng bên vôi hóa.
- Lao thứ phát:
- Đông đặc tại các phân thùy đỉnh của thùy trên hoặc phân thùy đỉnh của thùy dưới.
- Tạo hang
- Lan tràn qua đường phế quản:
- Hình ảnh “cành cây nảy chồi” (tree-in-bud)
- Lao kê:
- Các nốt 2-3 mm với phân bố ngẫu nhiên.
Hình bên trái là bệnh nhân lao phổi.
Có tổn thương tạo hang và hình ảnh “cành cây nảy chồi” điển hình.
Mũi tên màu xanh chỉ kim sinh thiết.
Lao kê (Miliary TB)
Đây là biểu hiện của sự phát tán nhiễm trùng theo đường máu, có thể xảy ra trong bối cảnh lao nguyên phát hoặc lao sau nguyên phát.
Đặc trưng bởi các nốt nhỏ đồng đều với phân bố ngẫu nhiên.
Tạo hang trong lao phổi
Phim X-quang ngực bên trái cho thấy các vùng đông đặc khoang khí dạng nốt lan tỏa.
HRCT chứng minh nhiều nốt phân bố quanh phế quản, một phần hợp lưu, và một ổ tạo hang ở phổi phải, gợi ý mạnh cho chẩn đoán lao phổi.
Các bệnh lý khác trong chẩn đoán phân biệt bao gồm u hạt Wegener hoặc ác tính (cả hai đều không có hình ảnh “cành cây nảy chồi”).
Lan tràn lao qua đường phế quản
Có thể xảy ra trong lao nguyên phát hoặc lao sau nguyên phát.
Ở hầu hết bệnh nhân, nhiễm trùng nguyên phát được khu trú và không có biểu hiện lâm sàng.
Tuy nhiên, ở 5 đến 10% bệnh nhân lao nguyên phát, nhiễm trùng không được kiểm soát tốt và xảy ra phát tán.
Tình trạng này được gọi là lao nguyên phát tiến triển.
Tạo hang lan rộng trong viêm phổi lao dẫn đến lan tràn nhiễm trùng qua đường phế quản.
Vỡ hạch bạch huyết hoại tử vào lòng phế quản cũng có thể gây phát tán qua đường phế quản.
Hình ảnh “cành cây nảy chồi” (tree-in-bud) là điển hình cho sự lan tràn nhiễm trùng qua đường phế quản đang hoạt động.
Hình ảnh này xuất hiện trong lao cấp tính nhưng cũng gặp trong bất kỳ nhiễm khuẩn nào khác.
Chẩn đoán phân biệt lao phổi.
- Lao nguyên phát: Viêm phổi vi khuẩn cấp tính
- Lao thứ phát: Sarcoidosis, Bụi phổi silic (Silicosis), Bệnh bụi phổi (Pneumoconiosis)
- Lao lan tràn qua đường phế quản: Viêm phế quản phổi, Viêm phổi quá mẫn
- Lao kê: Di căn từ ung thư tuyến giáp thể tủy, ung thư màng đệm (choriocarcinoma) và u hắc tố (melanoma).
Trong cả lao kê và di căn, các nốt đều có phân bố ngẫu nhiên.
Trong lao kê, các nốt đồng đều hơn về kích thước.
Hình ảnh
- Lao kê – các nốt nhỏ đồng đều phân bố ngẫu nhiên
- Di căn – các nốt có kích thước khác nhau phân bố ngẫu nhiên.
Viêm phổi tăng bạch cầu ái toan mạn tính
Viêm phổi tăng bạch cầu ái toan mạn tính là một bệnh lý vô căn, đặc trưng bởi sự lấp đầy các phế nang bởi bạch cầu ái toan.
Bệnh có liên quan đến tình trạng tăng số lượng bạch cầu ái toan trong máu ngoại vi; bệnh nhân thường biểu hiện với sốt, ho, sụt cân, mệt mỏi và khó thở.
Các triệu chứng thường nặng nề và kéo dài từ ba tháng trở lên.
Bệnh nhân đáp ứng nhanh chóng với điều trị bằng corticosteroid.
Hình ảnh HRCT trong viêm phổi tăng bạch cầu ái toan mạn tính
- Đông đặc ngoại vi với ưu thế ở thùy trên (hình ảnh âm bản của phù phổi).
Bên trái là hình ảnh CT có tiêm thuốc cản quang của một bệnh nhân viêm phổi tăng bạch cầu ái toan mạn tính.
Lưu ý phân bố ngoại vi của các vùng đông đặc.
Chẩn đoán phân biệt viêm phổi tăng bạch cầu ái toan mạn tính
- Viêm phổi tổ chức hóa (COP)
- Hội chứng Löffler (tăng bạch cầu ái toan và các vùng đông đặc ngoại vi thoáng qua)
- Hội chứng Churg-Strauss (cũng có tăng bạch cầu ái toan trong huyết thanh, hen phế quản, viêm mạch hệ thống ảnh hưởng nhiều cơ quan: suy thận, đau khớp, viêm cơ tim và viêm màng ngoài tim)
- Nhồi máu phổi
Các hình ảnh bên trái cho thấy sự tương đồng giữa viêm phổi tăng bạch cầu ái toan mạn tính và viêm phổi tổ chức hóa.
Việc phân biệt hai bệnh lý này cần dựa trên các dữ liệu lâm sàng và xét nghiệm.
Viêm phổi do Pneumocystis carinii
Viêm phổi do Pneumocystis carinii (PCP), hay còn gọi là Pneumocystis jiroveci theo danh pháp hiện hành, là một nhiễm trùng cơ hội xảy ra ở bệnh nhân suy giảm miễn dịch.
PCP từng ảnh hưởng đến hầu hết bệnh nhân nhiễm HIV ở một giai đoạn nào đó trong quá trình diễn tiến bệnh, tuy nhiên với sự ra đời của các thuốc kháng vi-rút thế hệ mới, bệnh đã trở nên ít gặp hơn.
Hiện nay, PCP được ghi nhận nhiều hơn ở các bệnh nhân ức chế miễn dịch, bao gồm bệnh nhân ghép tạng và bệnh nhân đang điều trị hóa chất.
Hình ảnh HRCT trong PCP
- Mờ dạng kính mờ (ground-glass opacification) quanh rốn phổi hoặc lan tỏa.
- Đôi khi có dày các đường vách liên tiểu thùy kết hợp với vùng kính mờ.
- Giai đoạn muộn xuất hiện nang (hoặc phế nang khí thũng – pneumatoceles) ở 10-35% bệnh nhân, thường ở thùy trên.
- Các nang có thể có hình dạng bất thường và thành dày.
- Sau điều trị, các tổn thương này dần thoái triển, có thể biến mất hoàn toàn hoặc để lại các nốt hay sẹo xơ tồn dư.
- Tràn khí màng phổi gặp ở 35% bệnh nhân có nang.
Hình bên trái là bệnh nhân suy giảm miễn dịch mắc PCP.
Hình ảnh CT cho thấy mờ dạng kính mờ lan tỏa.
Hình ảnh này không đặc hiệu cho PCP, nhưng trong bối cảnh lâm sàng này, PCP là chẩn đoán có khả năng cao nhất.
Hình bên trái là một bệnh nhân khác mắc PCP.
Cuộn qua các hình ảnh để xem.
ARDS
Hội chứng suy hô hấp cấp tiến triển (ARDS) là tình trạng suy hô hấp đột ngột, đe dọa tính mạng, đòi hỏi phải thở máy.
ARDS là hậu quả của tình trạng tăng tính thấm thành mạch, thường kết hợp với tổn thương biểu mô đường hô hấp.
Nhiều nguyên nhân khác nhau, từ nhiễm trùng đến chấn thương nặng, đều có thể gây ra ARDS.
Yếu tố nguy cơ từ phổi (nguyên phát) bao gồm hít sặc, viêm phổi, hít phải chất độc và đụng dập phổi.
Yếu tố nguy cơ ngoài phổi bao gồm nhiễm khuẩn huyết, viêm tụy, truyền máu nhiều lần, chấn thương và sử dụng các chất như heroin.
Các thể ARDS nhẹ có thể hồi phục hoàn toàn, trong khi các thể nặng dẫn đến xơ hóa không hồi phục.
Lý do tại sao một số người phát triển ARDS trong khi những người khác thì không vẫn chưa được biết rõ.
ARDS ngoài phổi
Hình bên trái là bệnh nhân bị tai nạn giao thông và trong vòng vài giờ đã phát triển ARDS.
Hình thái chiếm ưu thế là kính mờ (ground glass opacity).
Tại các vùng phụ thuộc trọng lực của phổi còn có thêm một số vùng đông đặc, tạo ra gradient từ trước ra sau.
Một đặc điểm quan trọng trong ARDS ngoài phổi là tính đối xứng của các bất thường.
ARDS tại phổi
Hình bên trái là bệnh nhân phát triển ARDS do viêm phổi (tức là ARDS tại phổi).
Lưu ý sự phân bố dạng đốm của tổn thương phổi và tình trạng biến dạng gần như hoàn toàn ở vùng đáy phổi.
Bệnh nhân được thở máy với PEEP (áp lực dương cuối thì thở ra) dẫn đến chấn thương áp lực (barotrauma) nhu mô phổi: có nhiều nang dưới màng phổi và tràn khí màng phổi hai bên.

TRÁI: ARDS. PHẢI: Xơ hóa vùng phổi trước do tổn thương liên quan đến chấn thương áp lực và thở máy PEEP
Các vùng đông đặc có tác dụng bảo vệ nhu mô phổi khỏi tác động của thở máy PEEP, trong khi các vùng phổi bình thường hơn nằm ở phía bụng (ventral) lại dễ bị ảnh hưởng nhất bởi chấn thương áp lực.
Hậu quả là chúng ta thấy tình trạng phá hủy dạng nang ở vùng bụng và xơ hóa tồn dư chủ yếu ở các vùng phổi phía bụng.
Viêm phổi mô kẽ vô căn
Viêm phổi mô kẽ vô căn (IIPs) bao gồm một nhóm các rối loạn không đồng nhất.
Chúng đại diện cho các đáp ứng cơ bản của phổi trước tổn thương và về bản chất không phải là các ‘bệnh lý’ theo nghĩa thông thường.
‘Vô căn’ có nghĩa là nguyên nhân chưa được xác định, còn ‘viêm phổi mô kẽ’ đề cập đến sự tổn thương nhu mô phổi với các mức độ kết hợp khác nhau giữa xơ hóa và viêm.
IIPs bao gồm bảy thực thể được liệt kê trong bảng bên trái theo thứ tự tần suất tương đối.
Các bệnh lý này có các dạng tổn thương hình thái học đặc trưng trên HRCT và mô bệnh học.
Trước khi gọi các tổn thương này là vô căn hay ẩn nguyên, cần nhận thức rằng các dạng tổn thương này cũng là những phát hiện thường gặp trong bệnh mô liên kết (ví dụ: xơ cứng bì, viêm khớp dạng thấp) và bệnh phổi do thuốc.
Chẳng hạn, ở bệnh nhân viêm khớp dạng thấp, người ta đã ghi nhận các dạng tổn thương NSIP, UIP, OP và LIP.
UIP
Viêm phổi mô kẽ thông thường (UIP) là một chẩn đoán mô bệnh học.
UIP có các đặc điểm HRCT đặc trưng và thường được xác nhận qua sinh thiết phổi khi có hình ảnh tổ ong.
Nếu dạng UIP không xác định được nguyên nhân (tức là vô căn), bệnh được gọi là Xơ phổi vô căn (IPF).
IPF chiếm hơn 60% các trường hợp UIP.
Khi sinh thiết phẫu thuật cho thấy dạng UIP, chẩn đoán IPF đòi hỏi phải loại trừ các nguyên nhân đã biết khác của UIP, bao gồm độc tính thuốc, phơi nhiễm môi trường (amiăng) và các bệnh mô liên kết như viêm khớp dạng thấp, lupus ban đỏ hệ thống, viêm đa động mạch nút và xơ cứng bì.
Nhiều loại thuốc đã được xác định có liên quan, nhưng dạng tổn thương này thường gặp nhất là hậu quả của các thuốc hóa trị liệu gây độc tế bào như bleomycin, busulfan, vincristine, methotrexate, adriamycin và carmustine (BCNU).
Việc phân biệt giữa NSIP và UIP có ý nghĩa tiên lượng rất lớn đối với bệnh nhân.
UIP tiến triển nặng hơn và hơn 50% bệnh nhân UIP tử vong trong vòng 3 năm.

Phim X-quang ngực của bệnh nhân UIP cho thấy dạng lưới ở vùng đáy phổi và dưới màng phổi do hình ảnh tổ ong.
Bên trái là phim X-quang ngực của bệnh nhân UIP do IPF.
Các dấu hiệu trên phim X-quang ngực bao gồm mất thể tích và các thay đổi xơ hóa ở vùng đáy phổi.
Hình ảnh X-quang của tổ ong bao gồm các đậm độ dạng lưới do thành dày của các nang.
Khi thấy phim X-quang ngực có hình lưới kéo dài với ưu thế ở thùy dưới và ngoại vi, hãy nghĩ đến ‘UIP’.
Dấu hiệu HRCT trong UIP
- Hình ảnh tổ ong gồm các nang thành dày nhiều lớp.
- Biến dạng cấu trúc với giãn phế quản do co kéo (traction bronchiectasis) do xơ hóa.
- Ưu thế ở vùng đáy phổi và dưới màng phổi.
- Hạch bạch huyết trung thất to nhẹ
Chẩn đoán phân biệt của UIP.
- Viêm phổi quá mẫn mạn tính
- Sarcoidosis giai đoạn cuối
- NSIP
Viêm phổi quá mẫn mạn tính có thể không phân biệt được với UIP.
Cần nghi ngờ chẩn đoán này khi có dạng khảm với vùng đáy phổi được bảo tồn hoặc khi có các nốt trung tâm tiểu thùy.
Sarcoidosis là chẩn đoán có khả năng hơn nếu xơ hóa khu trú ở phần sau của thùy trên hoặc vùng quanh rốn phổi, đồng thời có các nốt phân bố quanh bạch huyết hoặc hạch bạch huyết trung thất to lan rộng.
Sự hiện diện của mảng màng phổi giúp phân biệt giữa IPF và bệnh phổi do amiăng.
Bên trái là hình ảnh của bệnh nhân UIP.
Lưu ý hình ảnh tổ ong và ưu thế ở vùng dưới màng phổi và đáy phổi.
Thông thường, dạng UIP trên HRCT khá dễ nhận biết.
NSIP
Viêm phổi mô kẽ không đặc hiệu (NSIP) được một số tác giả coi là một thực thể bệnh lý riêng biệt với các đặc điểm mô bệnh học đặc trưng, nhưng một số khác lại xem đây là chẩn đoán ‘thùng rác’, đại diện cho các trường hợp viêm phổi mô kẽ vô căn không thể phân loại thành UIP, DIP hay OP.
Về mô bệnh học, NSIP được đặc trưng bởi dạng viêm mô kẽ tế bào đồng nhất, đồng đều kết hợp với các mức độ xơ hóa khác nhau.
Ngược lại, UIP liên quan đến xơ hóa lan rộng không đồng nhất về thời gian (tức là các tổn thương ở các giai đoạn tiến triển khác nhau).
NSIP là một nhóm rất không đồng nhất.
NSIP dao động từ type I với dạng tế bào biểu hiện là mờ kính mờ trên HRCT đến type IV với dạng xơ hóa, có thể không phân biệt được với UIP.
Bên trái là bệnh nhân NSIP.
Bệnh nhân này có biểu hiện ban da và yếu cơ.
Cuộn qua các hình ảnh.
Dấu hiệu chủ yếu là mờ kính mờ (GGO).
Có giãn phế quản do co kéo rất tinh tế, cho thấy GGO là hậu quả của xơ hóa và do đó không hồi phục.
Điều quan trọng cần lưu ý là chúng ta không thấy phân bố điển hình của UIP, vốn là bệnh cần phân biệt với NSIP.
Tiền sử của bệnh nhân này gợi ý chẩn đoán viêm da cơ (dermatomyositis).
NSIP là bệnh phổi mô kẽ phổ biến nhất ở bệnh nhân mắc bệnh mô liên kết.
NSIP (2)
NSIP không phải là một chẩn đoán độc lập.
Đây là một dạng tổn thương phổi.
Đối với nhà giải phẫu bệnh, đặc điểm then chốt là tính đồng nhất của bất thường trong phổi.
Vai trò của bác sĩ chẩn đoán hình ảnh là ‘loại trừ dạng UIP’ hơn là đưa ra chẩn đoán NSIP.
Chẩn đoán NSIP đòi hỏi phải có bằng chứng mô bệnh học.
Ở tất cả bệnh nhân có dạng NSIP, bác sĩ lâm sàng cần được tư vấn tìm kiếm bệnh mô liên kết, viêm phổi quá mẫn hoặc nguyên nhân do thuốc.
Bên trái là hai trường hợp NSIP.
Lưu ý sự kết hợp đa dạng giữa GGO và xơ hóa (giãn phế quản do co kéo), nhưng không có hình ảnh tổ ong.
NSIP (3)
NSIP là dạng tổn thương phổi chiếm ưu thế trong xơ cứng bì hệ thống và viêm đa cơ/viêm da cơ (hơn 90%), nhưng cũng có thể gặp trong viêm khớp dạng thấp, lupus ban đỏ hệ thống, hội chứng Sjögren và bệnh mô liên kết hỗn hợp.
Trong các hình ảnh bên trái, bạn có thể thấy lại phổ các dấu hiệu gặp trong NSIP.
Cả ba bệnh nhân đều mắc bệnh mô liên kết và tất cả các trường hợp đều được xác nhận bằng sinh thiết.
Trường hợp đầu tiên (trên bên trái) cho thấy GGO rất tinh tế.
Lưu ý sự khác biệt về tỷ trọng giữa không khí trong phế quản và nhu mô phổi xung quanh (dấu hiệu phế quản tối).
Trường hợp thứ hai (trên bên phải) là ví dụ rõ ràng hơn về GGO với các đậm độ dạng lưới mịn chồng lên do dày vách tiểu thùy.
Hình ảnh cuối cùng cũng cho thấy GGO với dạng lưới mịn.
Lưu ý sự vắng mặt của hình ảnh tổ ong trong cả ba trường hợp, loại trừ UIP là chẩn đoán.
NSIP (4)
HRCT của bệnh nhân xơ cứng bì và NSIP này cho thấy dạng lưới mịn dưới màng phổi ở thùy trên và các bất thường lan rộng hơn ở vùng phổi dưới.
Cũng có các vùng kính mờ và giãn phế quản do co kéo, nhưng hình ảnh tổ ong thường vắng mặt.
Lưu ý thực quản giãn nhẹ, phù hợp với xơ cứng bì.
COP
Viêm phổi tổ chức hóa ẩn nguyên (COP) trước đây được mô tả là viêm tiểu phế quản tắc nghẽn kết hợp viêm phổi tổ chức hóa (BOOP) trong phiên bản phân loại cũ của viêm phổi mô kẽ vô căn.
Đây là một quá trình viêm trong đó quá trình lành thương được đặc trưng bởi sự tổ chức hóa của dịch tiết thay vì tái hấp thu (‘viêm phổi không hồi phục’).
Viêm phổi tổ chức hóa chủ yếu là v
Bệnh phổi do thuốc
Bệnh phổi do thuốc là một nguyên nhân quan trọng gây tổn thương phổi do thầy thuốc.
Vấn đề chẩn đoán chủ yếu là bệnh có thể biểu hiện với nhiều dạng hình ảnh X-quang khác nhau.
Bệnh có thể biểu hiện dưới dạng viêm phổi tổ chức hóa, viêm phổi tăng bạch cầu ái toan, xơ hóa, viêm phổi quá mẫn hoặc thậm chí là ARDS.
Chẩn đoán bệnh phổi do thuốc thường là chẩn đoán loại trừ.
Hình bên trái là một bệnh nhân đang được điều trị bằng thuốc độc tế bào cho một bệnh lý ác tính huyết học.
Các dấu hiệu X-quang bao gồm các vùng kính mờ, một số giãn phế quản do co kéo và hình tổ ong mờ nhạt ở thùy dưới phổi trái.
Đây có thể là kết quả của một dạng xơ hóa vô căn như xơ phổi vô căn và viêm phổi kẽ không đặc hiệu, hoặc xơ hóa trong viêm phổi quá mẫn mạn tính và sarcoid giai đoạn muộn.
Tuy nhiên, đây không phải là một trong những dạng xơ hóa điển hình mà chúng ta thường gặp ở bệnh nhân có dạng UIP hoặc dạng NSIP thấy trong các bệnh collagen mạch máu.
Khi có xơ hóa không phù hợp với bất kỳ bệnh xơ hóa phổ biến nào, hãy luôn xem xét bệnh phổi do thuốc trong chẩn đoán phân biệt.
Viêm phổi tổ chức hóa do thuốc thường do Bleomycin và Cyclophosphamide gây ra, cùng với các thuốc khác như Methotrexate, Amiodarone, Nitrofurantoin và Penicillamine (9).
Các dấu hiệu trên HRCT tương tự như trong viêm phổi tổ chức hóa ẩn nguyên.
Viêm phổi kẽ không đặc hiệu (NSIP) do thuốc thường xảy ra nhất như một biểu hiện của độc tính carmustine hoặc độc tính từ các thuốc không phải độc tế bào như amiodarone.
Các dấu hiệu X-quang tương tự như trong các dạng NSIP khác.
Các bệnh phổi kẽ không thường gặp
Lymphangiomyomatosis
- Bệnh hiếm gặp, chỉ xảy ra ở phụ nữ tiền mãn kinh.
- Đặc trưng bởi sự tăng sinh tiến triển của các tế bào cơ trơn bất thường dọc theo các tiểu phế quản, dẫn đến bẫy khí và hình thành các nang thành mỏng thay thế nhu mô phổi bình thường.
- Các biến đổi phổi tương tự được ghi nhận ở 1% bệnh nhân mắc bệnh xơ cứng củ (chủ yếu ảnh hưởng đến nam giới trẻ tuổi).
Biểu hiện lâm sàng:
- Đa số bệnh nhân biểu hiện bằng khó thở.
- Tràn dịch màng phổi dưỡng chấp (40%), tràn khí màng phổi (40%), ho ra máu (40%).
- Bệnh nhân tử vong trong vòng 10 năm kể từ khi khởi phát triệu chứng.
- Thai kỳ có thể làm bệnh tiến triển nặng hơn.
Các dấu hiệu chính trong Lymphangiomyomatosis:
- Nhiều nang thành mỏng, được bao quanh bởi nhu mô phổi bình thường.
- Các nang có đường kính từ 2mm đến 5cm, hình tròn và tương đối đồng đều.
- Các nang phân bố lan tỏa khắp phổi, ảnh hưởng tương đương ở cả thùy trên và thùy dưới.
- Độ dày thành nang dao động từ hầu như không nhìn thấy đến 4mm.
- Hạch bạch huyết trung thất hoặc rốn phổi và tràn dịch màng phổi (40%).
- Tràn khí màng phổi tái phát (40%).
Bên trái là một trường hợp điển hình của LAM với nhiều nang thành mỏng phân bố đều, biến chứng tràn khí màng phổi.
Chẩn đoán phân biệt Lymphangiomyomatosis:
- Mô bào tế bào Langerhans: > 90% là người hút thuốc lá, các nang có hình dạng bất thường và các góc sườn hoành đáy phổi không bị ảnh hưởng.
- Khí phế thũng trung tiểu thùy: đặc trưng bởi các khoang khí không có thành rõ ràng, động mạch trung tiểu thùy xuất hiện dưới dạng chấm ở trung tâm.
- Viêm phổi kẽ dạng lympho: gặp ở bệnh nhân HIV và hội chứng Sjögren.
Bên trái là một trường hợp điển hình khác của LAM.
Mô bào tế bào Langerhans
Mô bào tế bào Langerhans còn được gọi là mô bào X phổi hoặc u hạt bạch cầu ái toan.
LCH có thể là một phản ứng dị ứng với khói thuốc lá vì hơn 90% bệnh nhân là người đang hút thuốc.
Ở giai đoạn nốt sớm, bệnh đặc trưng bởi phản ứng u hạt trung tiểu thùy do các mô bào Langerhans.
Ở giai đoạn nang, tắc nghẽn tiểu phế quản gây xơ hóa thành phế nang và hình thành nang.
Dấu hiệu HRCT trong mô bào tế bào Langerhans:
- Giai đoạn sớm:
- Các nốt nhỏ không đều hoặc hình sao ở vị trí trung tiểu thùy.
- Giai đoạn muộn (thường gặp hơn)
- Các khoang khí dạng nang. Các nang có hình dạng bất thường, có thể hợp lại và trở nên lớn hơn.
- Ưu thế ở thùy trên và thùy giữa.
- Tràn khí màng phổi tái phát.
Bên trái là mô bào tế bào Langerhans giai đoạn sớm với các nốt nhỏ.
Không có nang nào được nhìn thấy.

Mô bào tế bào Langerhans giai đoạn muộn. Các nang tiến triển thành nang hình dạng bất thường điển hình.
Ở giai đoạn muộn hơn, các nốt bắt đầu hoại tử tạo hang và trở thành nang.
Các nang này ban đầu có dạng hình tròn nhưng cuối cùng hợp lại tạo thành các nang hình dạng bất thường điển hình của LCH.
Ở bệnh nhân LCH, 95% có tiền sử hút thuốc lá.
Bên trái là sự tương quan giữa hình ảnh học và giải phẫu bệnh của mô bào tế bào Langerhans lần lượt ở giai đoạn nốt, giai đoạn nang sớm và giai đoạn nang muộn.
Bên trái là phim X-quang ngực của bệnh nhân 19 tuổi mắc mô bào tế bào Langerhans.
Dấu hiệu nổi bật trên phim X-quang ngực là hình ảnh lưới và đó là giới hạn có thể nhận định được.
Ngoài ra còn có hình ảnh ứ khí phổi.
Không thể nhận ra rằng hình ảnh này được gây ra bởi nhiều nang.
Đây là mô bào tế bào Langerhans giai đoạn muộn.
Chẩn đoán phân biệt khó khăn nhất ở bệnh nhân này là khí phế thũng trung tiểu thùy.
Tuy nhiên, khí phế thũng được định nghĩa là các khoang khí không có thành rõ ràng.
Thông thường chúng ta có thể nhận diện dấu hiệu chấm trung tâm.
Ưu thế ở thùy trên không hữu ích trong chẩn đoán phân biệt vì dấu hiệu này cũng gặp trong nhiều bệnh do hít phải và cả trong khí phế thũng.
Bên trái là một trường hợp khác của mô bào tế bào Langerhans.
Bệnh khởi đầu bằng các nốt nhỏ, tiến triển theo thời gian thành các nốt hoại tử tạo hang.
Cuối cùng sẽ tiến triển thành các nang hình dạng bất thường thay thế nhu mô phổi bình thường.
Video
Hình ảnh của một nam giới trẻ hút thuốc lá mắc mô bào tế bào Langerhans.
Lưu ý sự tiến triển trên lần chụp thứ hai sau 7 năm.
Chẩn đoán phân biệt mô bào tế bào Langerhans.
-
LCH dạng nốt:
- Sarcoidosis: phân bố quanh bạch huyết.
- Di căn: phân bố ngẫu nhiên.
- LCH dạng nang:
- LAM: nang hình tròn, phân bố đều ở phụ nữ trong độ tuổi sinh sản.
- Giãn phế quản dạng nang: ‘dấu hiệu nhẫn đeo dấu’.
- Khí phế thũng trung tiểu thùy: không có thành, chấm trung tâm.
- Viêm phổi kẽ dạng lympho (LIP).
Khí phế thũng nặng có thể bắt chước hình ảnh mô bào tế bào Langerhans.
Khi khí phế thũng lan rộng ra ngoài vùng trung tiểu thùy đến rìa tiểu thùy thứ cấp, hình ảnh có thể trông như nang có thành.
Ở bệnh nhân LCH, nhà giải phẫu bệnh có thể tìm thấy LCH, nhưng cũng có các vùng khí phế thũng, viêm tiểu phế quản hô hấp và thậm chí xơ hóa.
Do đó, các bệnh liên quan đến hút thuốc lá này không phải là các thực thể bệnh lý riêng biệt.
Protein phế nang
Protein phế nang là bệnh hiếm gặp, đặc trưng bởi sự lấp đầy các khoang phế nang bằng chất liệu dương tính với PAS do bất thường trong chuyển hóa surfactant.
Chẩn đoán dựa trên hình ảnh HRCT gợi ý (hình ảnh lát đá điên) và các đặc điểm đặc trưng của dịch rửa phế quản phế nang (BAL – Broncho Alveolar Lavage).
- Thường gặp ở độ tuổi từ 30 đến 50.
- Ho khan, sốt và khó thở nhẹ.
- Tiên lượng đã được cải thiện kể từ khi áp dụng điều trị bằng rửa phế quản phế nang.
Các dấu hiệu chính trong protein phế nang
- Hình ảnh lát đá điên: hình ảnh lưới chồng lên trên vùng kính mờ.
- Các vùng đục mờ dao động từ kính mờ đến đông đặc.
Bên trái là một trường hợp điển hình của protein phế nang với dày lan tỏa các vách liên tiểu thùy và nội tiểu thùy.
Điều này được giải thích bởi thực tế là chất liệu protein được đại thực bào vận chuyển từ khoang phế nang vào mô kẽ, do đó dẫn đến dày các vách.
Hình ảnh lát đá điên là một dấu hiệu khá không đặc hiệu.
Nhiều bệnh khác có thể biểu hiện với dấu hiệu này và được liệt kê trong chẩn đoán phân biệt.
Chẩn đoán phân biệt protein phế nang
-
Phù phổi không do tim:
ARDS, Viêm phổi kẽ cấp tính. -
Viêm phổi:
- Nhiễm trùng (PCP và CMV).
- Viêm phổi tổ chức hóa (OP).
- Viêm phổi tăng bạch cầu ái toan mạn tính.
- Xuất huyết phổi.
- Ung thư phế quản phế nang.
Lời cảm ơn đặc biệt
Các tác giả xin trân trọng cảm ơn Bác sĩ Sujal Desai tại Bệnh viện King’s College ở London vì những bài giảng truyền cảm hứng của ông.
Một số hình ảnh được sử dụng trong tổng quan này do ông cung cấp.
Chúng tôi cũng xin cảm ơn Bác sĩ Richard Webb đã tạo ra một đĩa CD giáo dục tuyệt vời (1).